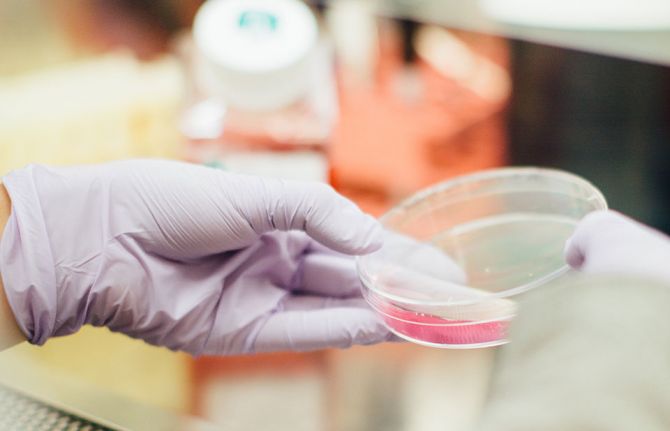

Los países deben intensificar urgentemente la transformación de sus respuestas al VIH en medio de una crisis de financiación internacional que pone en riesgo millones de vidas. MÁS INFORMACIÓN
EL SIDA EN CIFRAS
Hay una ralentización en el ritmo al cual se van reduciendo las nuevas infecciones por el VIH, se va aumentando el acceso al tratamiento y se va terminando con las muertes relacionadas con el sida. Comprueba los últimos datos (al cierre de 2023) con relación al VIH.


Hoja de ruta para que el mundo logre para el año 2030 acabar con el sida como amenaza a la salud pública.

Las leyes punitivas han demostrado bloquear el acceso a los servicios para el VIH, así como incrementar el riesgo de infectarse por el virus.


Los medicamentos de acción prolongada para la prevención y el tratamiento del VIH (aquellos que se pueden tomar cada pocos meses en lugar de diariamente) podrían ayudar a salvar muchas vidas y a acabar con la pandemia de sida si, a medida que se desarrollan, se ponen a disposición a gran escala.
Descubra el trabajo que lleva a cabo ONUSIDA para poner fin a la epidemia de sida como amenaza para la salud pública para 2030 sin que nadie quede excluido.



Explore
Discover more about UNAIDS’ work. Click here to access a collection of stories, videos, publications, infographics and more